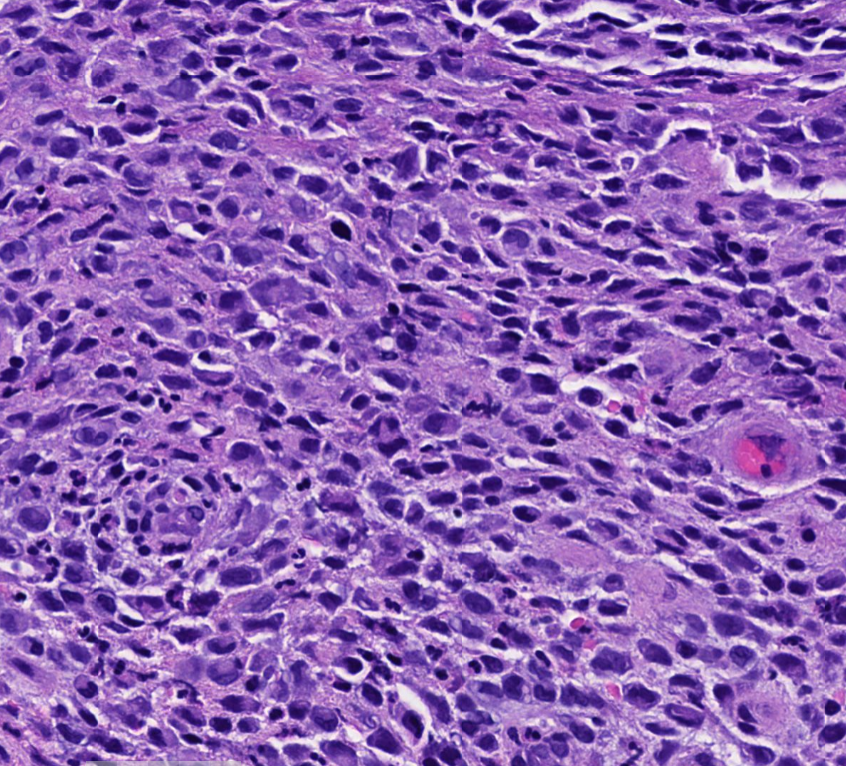
Janiranavarro's tweet image. GI-Unexpected Findings in Small Biopsies
Anal ulcer 78 yo Male

S100+, Melanoma..?
Case signed as Melanoma but molecular test showed BRAF mutation which is rare in mucosal melanomas
New stains: Langerin and CD1a positive...

Final Diagnosis: Langherhans cell hystiocytosis

DP
@nerdyDP
The heaviest property our body is not Weight. It is Ego. 😀When we stop learning we die, at least inside.
You might like
I like this post 👍👍👍
GI-Unexpected Findings in Small Biopsies Anal ulcer 78 yo Male S100+, Melanoma..? Case signed as Melanoma but molecular test showed BRAF mutation which is rare in mucosal melanomas New stains: Langerin and CD1a positive... Final Diagnosis: Langherhans cell hystiocytosis

Nice illustration
Non-invasive follicular thyroid neoplasm with papillary-like nuclear features (NIFTP) "An encapsulated/well demarcated neoplasm with follicular-patterned morphology and variable nuclear features of PTC, without capsular or vascular invasion" -No well-formed papillae -No psammoma


Nice 😊
Esophagus-duplicated muscularis mucosae Dr. Bell #CAP24 #pathology #pathologists #PathTwitter #PathX #pathresidents #pathfellow #GIpath



#Dermpath #Pathology Why is it required for pathologists to notify the clinicians diagnoses of melanoma and MIS? I assume they will check the path results after their procedures. We are not required to call for colon , bladder cancer etc .unless it’s unexpected. Thoughts ?
I don’t quite understand this pathology comment “ the lesion appears to be removed” I assume whoever did the biopsy knows it was removed in the office. Lol
Two most challenging skills in #pathology: 👉To be able to recognize a benign-appearing malignancy 👉 To be able to recognize a malignant-appearing benign.
Dermatopathologists waiting for the clinical pictures and information from clinicians. #dermpath #dermatopathology

R/o atypical nevus. Biopsy looks ok not exciting 😏. But IHC result changes the deal 🥳🥳🥳 Want to guess what the stain is?




18 yo F. L 2nd toe erythematous bumps and sores




Learn the basic #pathology features of #melanoma in my video: kikoxp.com/posts/3764. Here's a video on nevus basics too: kikoxp.com/posts/3740. Learn maturation, pagetoid, confluence, etc. #Pathology #dermpath #dermatology #dermtwitter #pathologists #pathTwitter #usmle #MedEd


Most melanocytic skin lesions can be diagnosed by H&E, but in some cases, immunostains can be very useful. This video shows my basic approach to using #IHCpath to help distinguish nevus from #melanoma. buff.ly/2NzAoLf #dermpath #Pathology #dermatology

Ladies and Gentlemen - if this doesn't blow your mind, nothing ever will! History of small bowel perforation. Enjoy! #GIPath PS Since Masala Dosas seem to be the flavor of the day - that's what you get if you diagnose this entity!




Fordyce granules. Foreskin from a 30-year-old presenting with Phimosis. These are ectopic sebaceous glands characterized by yellowish white popular lesions.Typically occurs in oral cavity but can also occur in penis! @UTSW_GUPath


United States Trends
- 1. Lakers N/A
- 2. Tourette N/A
- 3. Kash N/A
- 4. Pritchard N/A
- 5. #RHOP N/A
- 6. Celtics N/A
- 7. #BaddiesUSA N/A
- 8. FBI Director N/A
- 9. #married2med N/A
- 10. El Mencho N/A
- 11. Luka N/A
- 12. Jassi N/A
- 13. Pat Riley N/A
- 14. Canadians N/A
- 15. Puerto Vallarta N/A
- 16. #90DayFiance N/A
- 17. México N/A
- 18. Jaylen Brown N/A
- 19. Marcus Smart N/A
- 20. Cartel N/A
Something went wrong.
Something went wrong.





























































































































